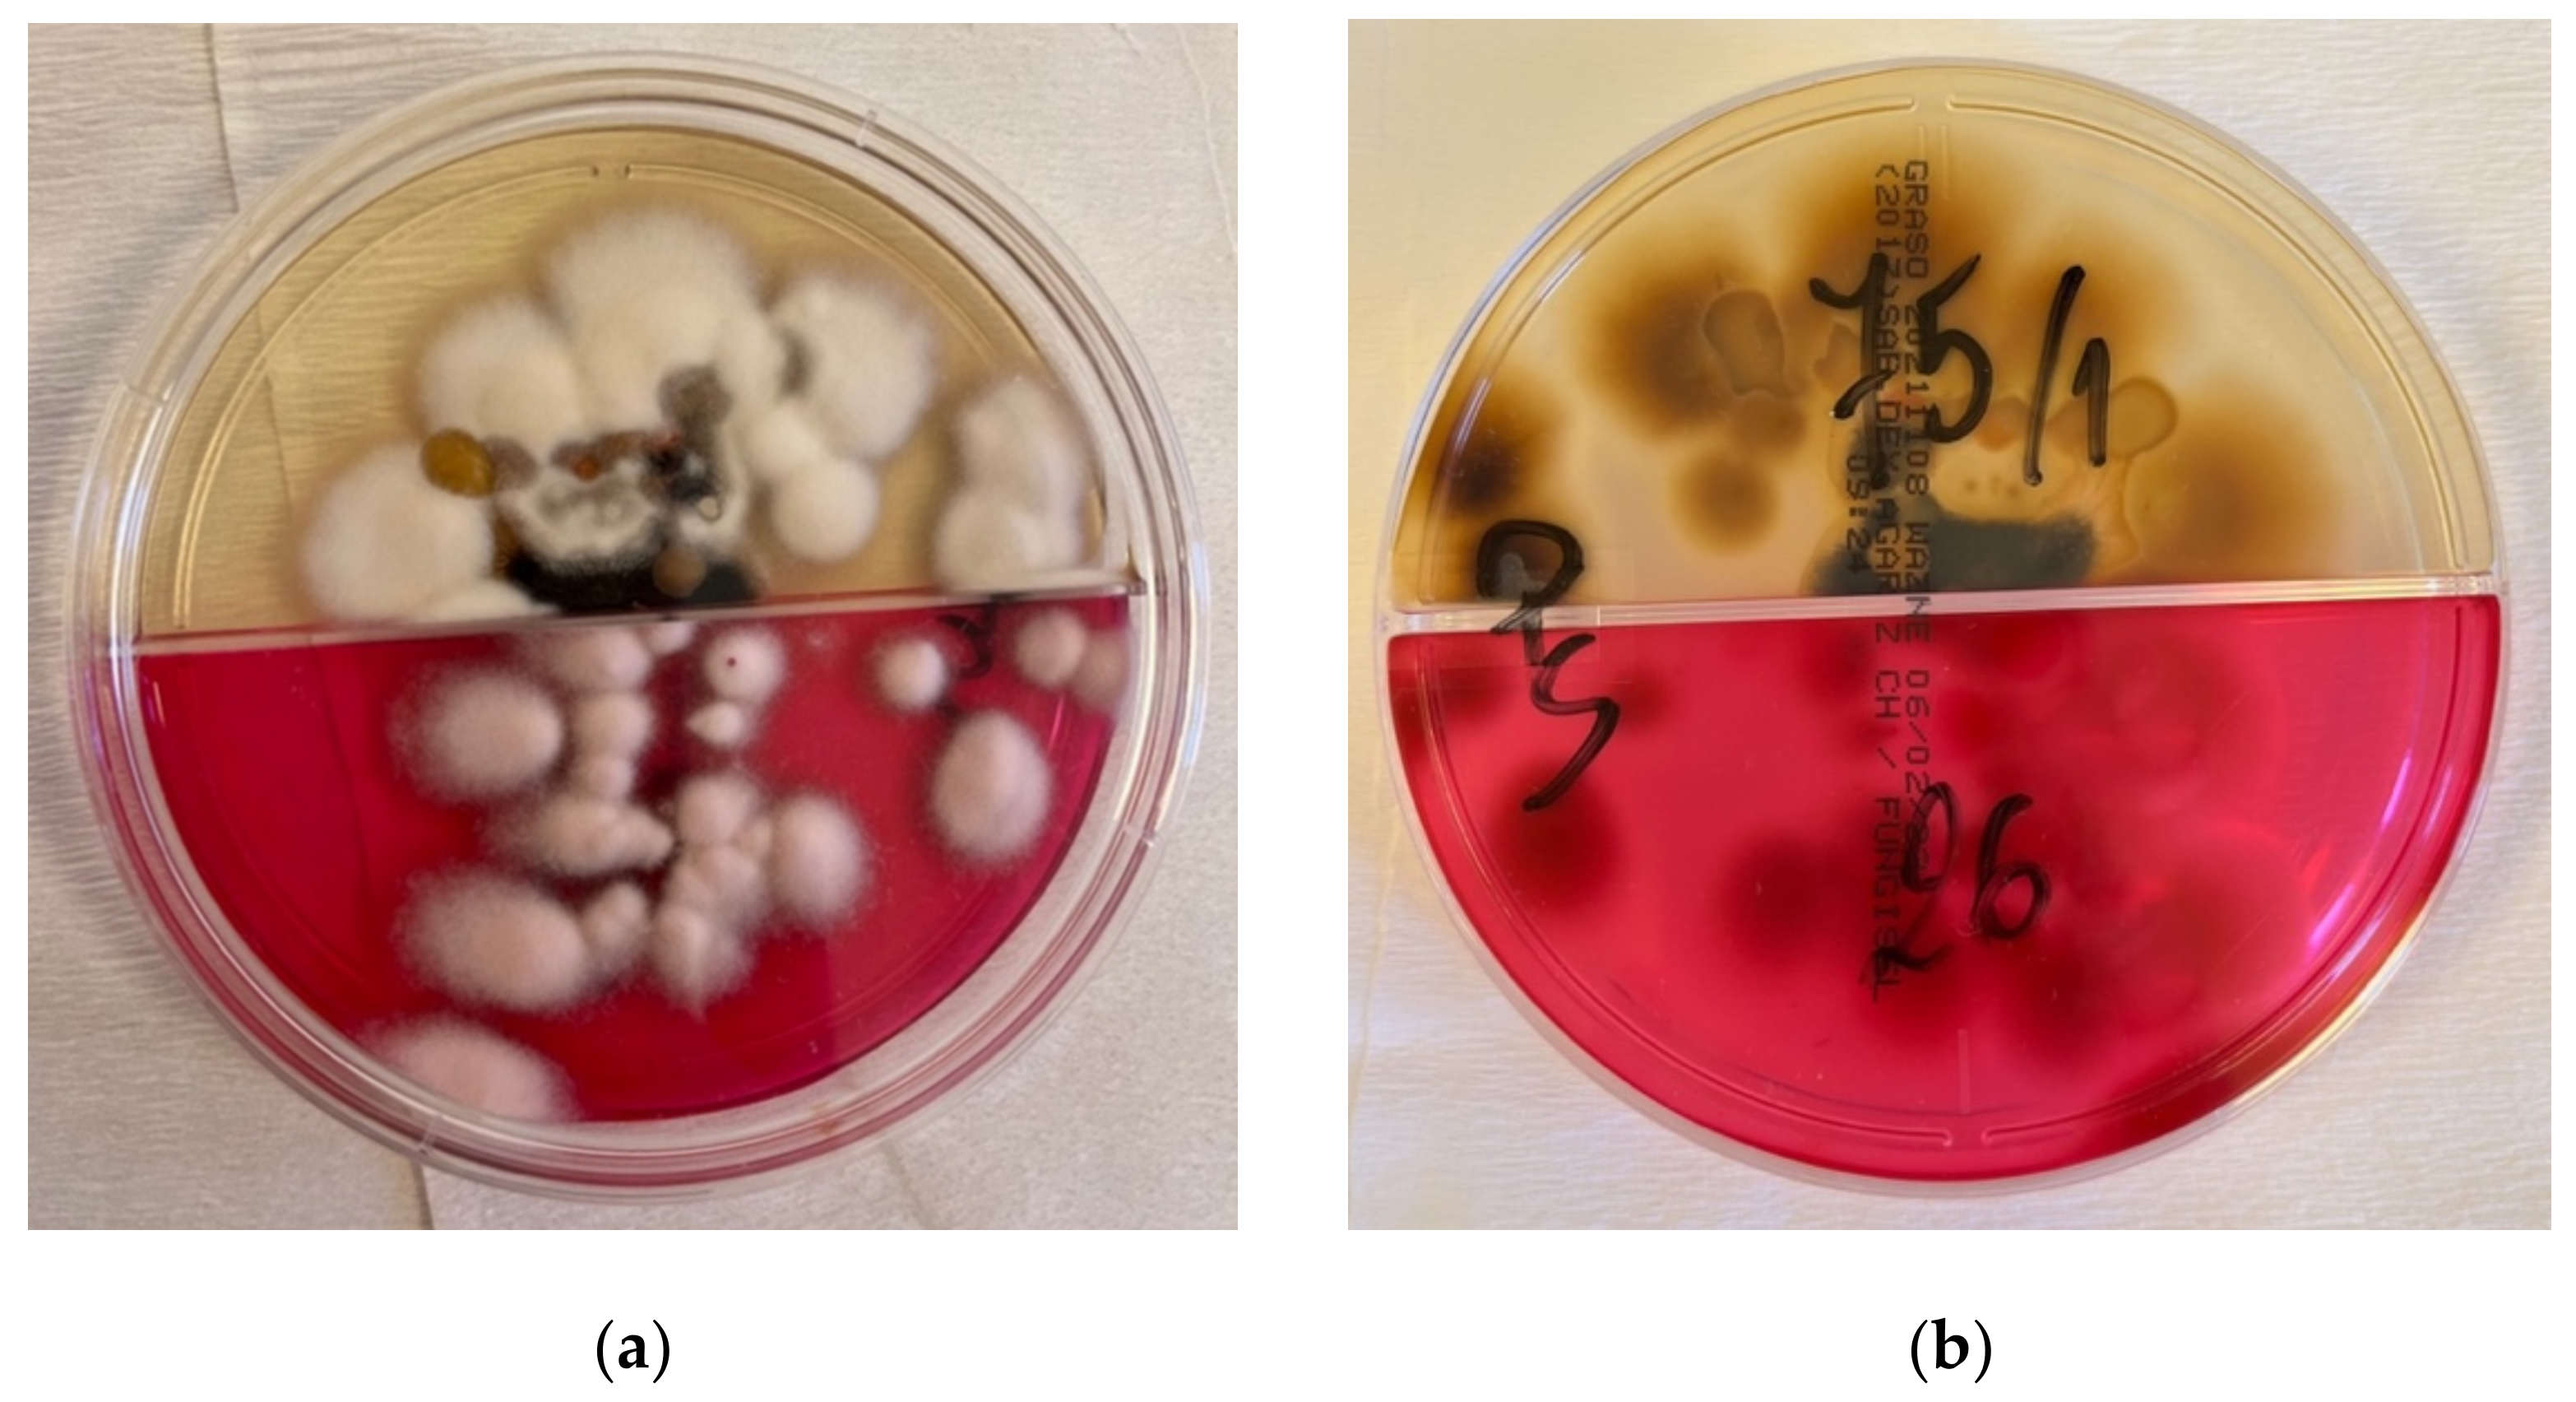
Jof 08 00312 g004 550

Tinea Incognito—A Great Physician Pitfall
Abstract
:1. Introduction
2. Case Description
3. Discussion
4. Conclusions
Supplementary Materials
Author Contributions
Funding
Institutional Review Board Statement
Informed Consent Statement
Data Availability Statement
Conflicts of Interest
References
- Seitz, A.T.; Paasch, U.; Simon, J.C.; Ziemer, M. Tinea incognito. J. Dtsch. Dermatol. Ges. 2013, 11, 1090–1093. [Google Scholar] [CrossRef] [PubMed]
- Lekkas, D.; Ioannides, D.; Lazaridou, E.; Lallas, A.; Apalla, Z.; Vakirlis, E.; Johr, R.; Errichetti, E.; Kyrgidis, A.; Sotiriou, E. Dermatoscopy of tinea corporis. J. Eur. Acad. Dermatol. Venereol. 2020, 34, e278–e280. [Google Scholar] [CrossRef] [PubMed]
- Yee, G.; Al Aboud, A.M. Tinea Corporis. In StatPearls; StatPearls Publishing: Treasure Island, FL, USA, 2022. [Google Scholar]
- Kim, M.W.; Park, H.S.; Bae, J.M.; Yoon, H.S.; Cho, S. Tinea Incognito with Folliculitis-Like Presentation: A Case Series. Ann. Dermatol. 2018, 30, 97–99. [Google Scholar] [CrossRef] [PubMed] [Green Version]
- Gawdzik, A.; Nowogrodzka, K.; Hryncewicz-Gwóźdź, A.; Maj, J.; Szepietowski, J.; Jankowska-Konsur, A. Epidemiology of dermatomycoses in southwest Poland, years 2011–2016. Adv. Dermatol. Alergol. 2019, 36, 604–608. [Google Scholar] [CrossRef] [PubMed]
- Froidefond, M.; Dudouet, P.; Ranque, S.; Cassir, N. Tinea incognito: Primum non nocere. Int. J. Infect. Dis. 2021, 103, 597–598. [Google Scholar] [CrossRef] [PubMed]
- Ilkit, M.; Karakaş, M.; Yüksel, T. A tinea incognito case caused by Trichophyton rubrum with clinical and mycological cure and review of the literature. Mikrobiyoloji Bul. 2010, 44, 149–153. [Google Scholar]
- Siddaiah, N.; Erickson, Q.; Miller, G.; Elston, D.M. Tacrolimus-induced tinea incognito. Cutis 2004, 7, 237–238. [Google Scholar]
- Ive, F.A.; Marks, R. Tinea incognito. Br. Med. J. 1968, 3, 149–152. [Google Scholar] [CrossRef] [PubMed] [Green Version]
- Park, Y.W.; Choi, J.W.; Paik, S.H.; Kim, D.Y.; Jin, S.-P.; Park, H.S.; Yoon, H.-S.; Cho, S. Tinea incognito simulating herpes simplex virus infection. Ann. Dermatol. 2014, 26, 267–269. [Google Scholar] [CrossRef] [PubMed] [Green Version]
- Romano, C.; Maritati, E.; Gianni, C. Tinea incognito in Italy: A 15-year survey. Mycoses 2006, 49, 383–387. [Google Scholar] [CrossRef] [PubMed]
- Arenas, R.; Moreno-Coutiño, G.; Vera, L.; Welsh, O. Tinea incognito. Clin. Dermatol. 2010, 28, 137–139. [Google Scholar] [CrossRef] [PubMed]
- Kim, W.J.; Kim, T.W.; Mun, J.H.; Song, M.; Kim, H.-S.; Ko, H.-C.; Kim, B.-S.; Park, C.W.; Lee, S.-J.; Lee, M.-H.; et al. Tinea incognito in Korea and its risk factors: Nine-year multicenter survey. J. Korean Med. Sci. 2013, 28, 145–151. [Google Scholar] [CrossRef] [PubMed]
- Paloni, G.; Valerio, E.; Berti, I.; Cutrone, M. Tinea Incognito. J. Pediatr. 2015, 167, 1450-e2. [Google Scholar] [CrossRef] [PubMed]
- Tchernev, G.; Terziev, I. Bullous Tinea Incognito in a Bulgarian Child: First Description in the Medical Literature! Open Access Maced. J. Med. Sci. 2018, 6, 376–377. [Google Scholar] [CrossRef] [PubMed] [Green Version]
- Amina, A.; Sana, M. Tinea Faciei Incognito. Indian Pediatr. 2019, 56, 433. [Google Scholar] [CrossRef] [PubMed] [Green Version]
- Atzori, L.; Pau, M.; Aste, N.; Aste, N. Dermatophyte infections mimicking other skin diseases: A 154-person case survey of tinea atypica in the district of Cagliari (Italy). Int. J. Dermatol. 2012, 51, 410–415. [Google Scholar] [CrossRef] [PubMed]
- Dhaher, S. Tinea incognito: Clinical perspectives of a new imitator. Dermatol. Rep. 2020, 12, 8323. [Google Scholar] [CrossRef] [PubMed]
- Dutta, B.; Rasul, E.S.; Boro, B. Clinico-epidemiological study of tinea incognito with microbiological correlation. Indian J. Dermatol. Venereol. Leprol. 2017, 83, 326–331. [Google Scholar] [CrossRef] [PubMed]
- Turan, E.; Erdemir, A.T.; Gurel, M.S.; Yurt, N. A new diagnostic technique for tinea incognito: In vivo reflectance confocal microscopy. Report of five cases. Skin Res. Technol. 2013, 19, e103–e107. [Google Scholar] [CrossRef] [PubMed]
- Park, Y.W.; Kim, D.Y.; Yoon, S.Y.; Park, G.Y.; Park, H.S.; Yoon, H.-S.; Cho, S. ‘Clues’ for the histological diagnosis of tinea: How reliable are they? Ann. Dermatol. 2014, 26, 286–288. [Google Scholar] [CrossRef] [PubMed] [Green Version]
- Summary of the Product Characteristics: Itraconazole. Available online: https://leki.urpl.gov.pl/files/Orungal_kaps_100mg.pdf (accessed on 25 February 2022).
- Summary of the Product Characteristics: Terbinafine. Available online: https://leki.urpl.gov.pl/files/21_Myconafine_250mg.pdf (accessed on 25 February 2022).

Publisher’s Note: MDPI stays neutral with regard to jurisdictional claims in published maps and institutional affiliations. |
© 2022 by the authors. Licensee MDPI, Basel, Switzerland. This article is an open access article distributed under the terms and conditions of the Creative Commons Attribution (CC BY) license (https://creativecommons.org/licenses/by/4.0/).
Share and Cite
Nowowiejska, J.; Baran, A.; Flisiak, I. Tinea Incognito—A Great Physician Pitfall. J. Fungi 2022, 8, 312. https://doi.org/10.3390/jof8030312
Nowowiejska J, Baran A, Flisiak I. Tinea Incognito—A Great Physician Pitfall. Journal of Fungi. 2022; 8(3):312. https://doi.org/10.3390/jof8030312
Chicago/Turabian StyleNowowiejska, Julia, Anna Baran, and Iwona Flisiak. 2022. "Tinea Incognito—A Great Physician Pitfall" Journal of Fungi 8, no. 3: 312. https://doi.org/10.3390/jof8030312
APA StyleNowowiejska, J., Baran, A., & Flisiak, I. (2022). Tinea Incognito—A Great Physician Pitfall. Journal of Fungi, 8(3), 312. https://doi.org/10.3390/jof8030312
